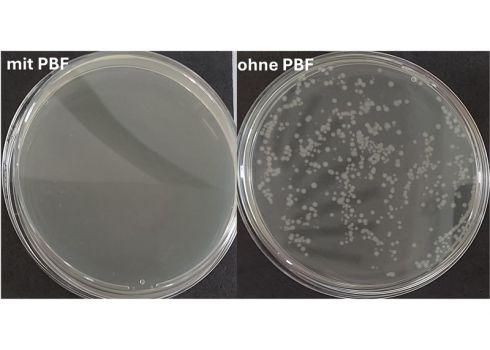

Chemikalienfreie Desinfektion durch Plasma-Technologie
Das Fraunhofer FEP untersucht plasmaaktiviertes Wasser als chemikalienfreie Alternative zu herkömmlichen Desinfektionsmitteln. Die innovative Lösung bleibt über 300 Tage aktiv und eignet sich für Pharmazie, Lebensmittelindustrie und Landwirtschaft.
Wissenschaftler des Fraunhofer FEP forschen an einer Technologie zur Herstellung von plasmabehandelten Flüssigkeiten (PBF), die als umweltfreundliche Alternative zu herkömmlichen chemischen Desinfektionsmitteln eingesetzt werden können. In einer aktuellen Studie wird deren Eignung als Oberflächendesinfektionsmittel untersucht. Die Forschungsergebnisse zeigen eine Haltbarkeit von über 10 Monaten und eine gute antimikrobielle Wirksamkeit gegen E. coli.
Die Technologie nutzt Atmosphärendruck-Plasmaquellen zur Behandlung von Flüssigkeiten, wodurch reaktive Sauerstoff- und Stickstoffspezies entstehen. Wie Linda Steinhäußer, Hauptautorin der Studie des Fraunhofer FEP, erläutert, kann das plasmaaktivierte Wasser vorab behandelt und dann zum Einsatzort transportiert werden, ohne dass Plasmaquellen oder andere Behandlungsgeräte vor Ort benötigt werden.
Vergleich verschiedener Plasma-Verfahren
Im Vergleich zweier Plasmaverfahren zeigte die Bogenentladung eine bis zu vierfach höhere antimikrobielle Wirksamkeit gegenüber der dielektrischen Barriereentladung. Die Tests mit dem Modellorganismus E. coli zeigten eine Reduktion von bis zu 4 log-Stufen, abhängig von Material, Einwirkzeit und verwendetem PBF-Volumen.
Vielseitige Anwendungsmöglichkeiten
Die plasmabehandelten Flüssigkeiten eignen sich für den Einsatz in unterschiedliche Branchen, wie beispielsweise:
- Pharmazie und Reinräume: Chemikalienfreie Desinfektion unter sterilen Bedingungen
- Lebensmittelindustrie: Cleaning-in-Place-Verfahren, z.B. für Milchtanks und ähnliche Anlagen
- Landwirtschaft: Mögliche Nutzung als Desinfektions- und Düngemittel durch Stickstoffspezies
Materialabhängige Wirksamkeit nachgewiesen
Die Studie dokumentiert erstmals eine materialabhängige antimikrobielle Wirksamkeit. Dafür wurden Polymeroberflächen (ABS, PVC) und Edelstahloberflächen vergleichend untersucht. Diese Erkenntnisse sind für die industrielle Anwendung relevant und ermöglichen eine gezielte Optimierung für verschiedene Oberflächenmaterialien und Einsatzszenarien.
Lagerstabilität untersucht
Die physikalisch-chemischen Parameter zeigen eine Haltbarkeit von über 300 Tagen bei längeren Plasma-Behandlungszeiten, so Steinhäußer. Während die Langzeitstabilität der physikalisch-chemischen Parameter nachgewiesen ist, wird die Korrelation mit der Desinfektionswirkung noch untersucht. Das Fraunhofer-Team arbeitet bereits mit Partnern aus der Pharmaindustrie zusammen und ist offen für weitere Kooperationen.
Über die Forschung
Die Studie wurde in der Fachzeitschrift Surface & Coatings Technology veröffentlicht und entstand in Zusammenarbeit zwischen dem Fraunhofer-Institut für Elektronenstrahl- und Plasmatechnik FEP in Dresden und dem Fraunhofer-Institut für Schicht- und Oberflächentechnik IST in Braunschweig.
Link zur Studie: https://www.sciencedirect.com/science/article/pii/S0257897225003664
Näheres auf der parts2clean 2025
Die Technologie wird auf der parts2clean Gemeinschaftsstand des Fraunhofer Geschäftsbereich Reinigung (Halle 10, Stand E28) präsentiert, wo ein Exponat die Plasmabehandlungstechnologie demonstriert. Zudem hält Linda Steinhäußer am 8. Oktober 2025, 12:00 Uhr, zu dem Thema einen Vortrag auf dem Vortragsforum der Messe: Plasmabehandelte Flüssigkeiten als nachhaltige Methode für Reinigungsprozesse.
Zum FEP
Das Fraunhofer-Institut für Elektronenstrahl- und Plasmatechnik FEP arbeitet an innovativen Lösungen für die Vakuumbeschichtung sowie die Behandlung von Oberflächen, Flüssigkeiten und Gasen. Aufbauend auf der Kernkompetenzen Elektronenstrahltechnologie, Magnetronsputtern und plasmaunterstützten Oberflächenverfahren entwickeln das Institut ressourceneffiziente Prozesstechnologien. Diese Technologien finden Anwendung in den Bereichen Energie und Nachhaltigkeit, Life Sciences, Umwelttechnologien, Smart Building und Digitalisierung. Das Fraunhofer FEP ermöglicht ein breites Spektrum an Forschungs-, Entwicklungs- und Pilotfertigungsmöglichkeiten, insbesondere für die Oberflächenbehandlung und Veredelung. Gemeinsam mit Partnern entstehen maßgeschneiderte, industrietaugliche Lösungen, die das Innovationspotenzial zukunfts- weisender Beschichtungstechnologien ausschöpfen und für die Produktion von morgen nutzbar machen.
Aktuelle Onlineartikel
-

20. 05. 2026 Biologisches Recycling von Elektroschrott zeigt großes Potenzial
-

11. 05. 2026 Fluorfreie Trockenbeschichtung für leistungsfähige Batterien
-

11. 05. 2026 Laserdirektplattieren senkt Taktzeit und Kosten für dicke Metallbeschichtungen
-

27. 04. 2026 Warum kommt es zu Kurzschlüssen in Festkörper-Batterien?
-

27. 04. 2026 Neuer internationaler Masterstudiengang „Battery Technologies“ startet zum Wintersemester 2026/27
-

27. 04. 2026 Nanofiltration – Wasser wirksam von Glyphosat befreien